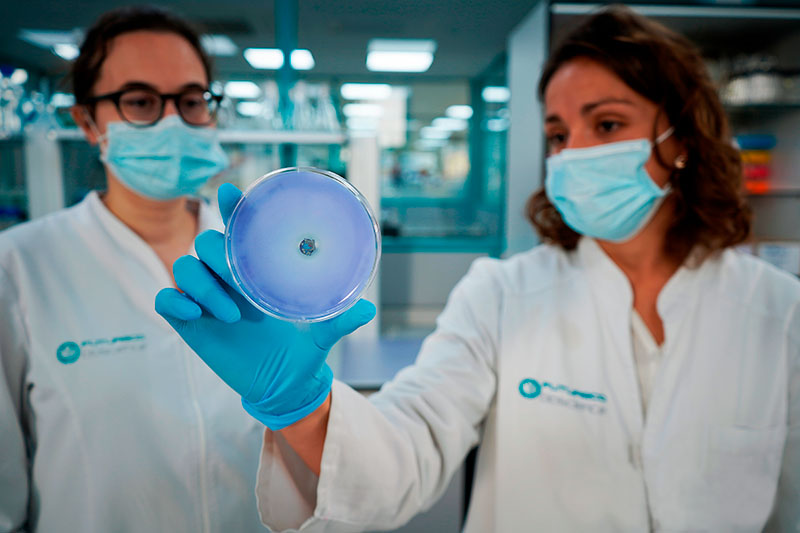
agriculture-biologique

Le passage des méthodes traditionnelles utilisant pesticides et engrais chimiques aux produits biologiques dans l’agriculture n’est pas seulement une tendance, mais une étape nécessaire vers la durabilité. Nous explorons ici les avantages de l’adoption de l’agriculture biologique, notamment avec des produits développés par Futureco Bioscience, un leader dans ce domaine. Ce changement promet des avantages significatifs pour la productivité des cultures, la santé de l’environnement et le bien-être de la société.
1. L’innovation au centre
Futureco Bioscience est à la pointe de l’innovation grâce à son engagement inébranlable en faveur des produits pour l’agriculture biologique et de sa recherche et développement. L’intégration des avancées biotechnologiques dans ses produits garantit qu’ils ne sont pas seulement efficaces, mais également en amélioration continue pour répondre aux besoins de l’agriculture moderne avec de nouvelles solutions.
2. Efficacité prouvée
L’une des principales préoccupations lors du passage aux produits biologiques pour l’agriculture est celle de l’efficacité. Futureco Bioscience répond directement à cette préoccupation, proposant des produits qui égalent ou surpassent les performances des solutions chimiques traditionnelles. Des tests rigoureux, réalisés tant en laboratoire que sur le terrain, démontrent que ces produits biologiques ne compromettent pas l’efficacité, assurant ainsi une productivité élevée sans produits chimiques nocifs.

3. Une qualité sans compromis
La qualité, particulièrement pour les produits destinés à l’agriculture biologique, est essentielle, et Futureco Bioscience excelle dans la formulation de produits de haute qualité. Ses produits garantissent des caractéristiques optimales de solubilité, de manipulation et d’applicabilité. En outre, les propriétés du produit sont maintenues pendant le stockage, prolongeant ainsi la durée de conservation et réduisant les déchets.

4. Préservation des ressources naturelles
L’accent mis par Futureco Bioscience sur l’utilisation intelligente et innovante des ressources naturelles contribue à renforcer le potentiel intrinsèque des cultures. En préservant les propriétés et les équilibres naturels, les produits de Futureco Bioscience garantissent que le sol n’est pas vidé de ses nutriments, ce qui permet non seulement de créer un environnement agricole durable, mais aussi de préserver la santé du sol, assurant ainsi une productivité à long terme et un équilibre écologique.
5. Engagement en faveur de la durabilité
La durabilité est peut-être le facteur le plus important dans le passage aux produits pour l’agriculture biologique. Les produits de Futureco Bioscience ne contiennent pas de résidus nocifs pour la santé des sols et sont facilement biodégradables. Cette approche protège la faune locale et les insectes bénéfiques tels que les abeilles, essentiels à la pollinisation et à la biodiversité. En outre, son nouvel emballage écologique représente une étape importante dans la réduction de l’impact sur l’environnement.